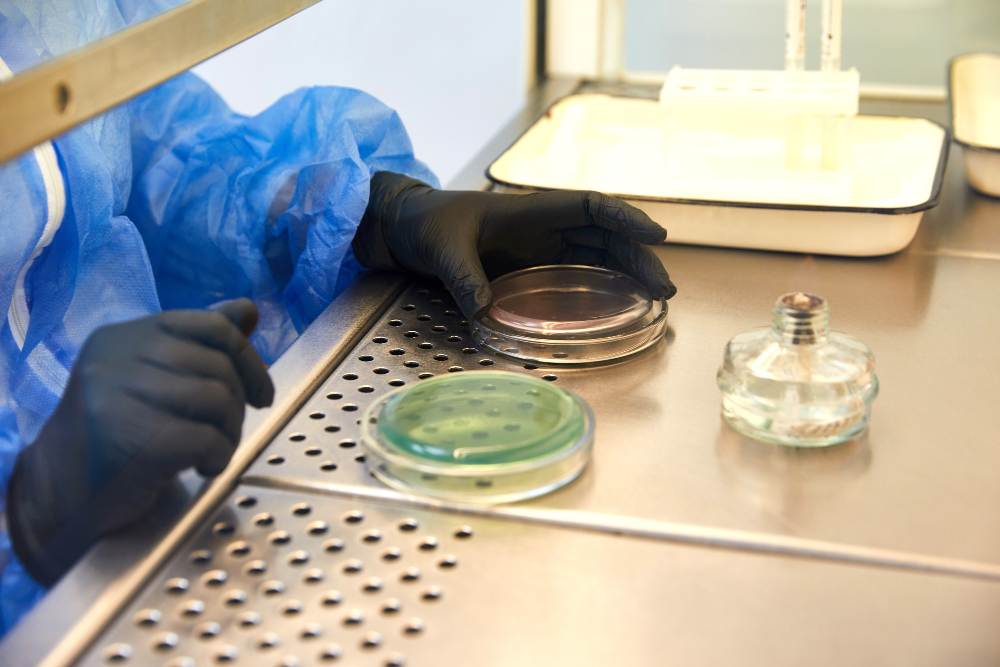
Mikrobiyoloji

Mikrobiyoloji
Lab Partner, titiz test ve doğrulama süreçleriyle ürünlerinizin sterilliğini ve mikrobiyal güvenliğini sağlamaya kendini adamıştır. Tıbbi cihaz sektörünün ihtiyaç duyduğu tüm belgelendirme, danışmanlık ve uyumluluk süreçlerinde yanınızdayız. Sunduğumuz mikrobiyolojik test hizmetleri kapsamında, tıbbi cihazların uluslararası standartlara uygunluğunu doğrulamak için titizlikle süreçler yürütüyoruz.
Lab Partner, titiz test ve doğrulama süreçleriyle ürünlerinizin sterilliğini ve mikrobiyal güvenliğini sağlamaya kendini adamıştır. Tıbbi cihaz sektörünün ihtiyaç duyduğu tüm belgelendirme, danışmanlık ve uyumluluk süreçlerinde yanınızdayız. Sunduğumuz mikrobiyolojik test hizmetleri kapsamında, tıbbi cihazların uluslararası standartlara uygunluğunu doğrulamak için titizlikle süreçler yürütüyoruz.
Mikrobiyolojik testler, genel ürün güvenliğini sağlamanın kritik bir parçasıdır. Lab Partner'ın sunduğu mikrobiyoloji hizmetleri şunları içerir:
- Ürün Sterilitesi: Mikrobiyolojik testler ile ürünlerin steril olduğunu ve mikrobiyal açıdan güvenli olduğunu doğruluyoruz.
- Mikrobiyolojik Testler: Güvenlik, kalite ve düzenleyici gerekliliklere uygunluğu değerlendirmek için kapsamlı mikrobiyolojik test yöntemleri sunuyoruz.
Mikrobiyoloji alanındaki uzmanlığımız, gelişen gereksinimler ve endüstri beklentileri hakkında derin bir anlayışa dayanmaktadır. Ürünlerinizin güvenli bir şekilde pazara sunulmasını sağlamak için her adımda güvenebileceğiniz bir ortağız.